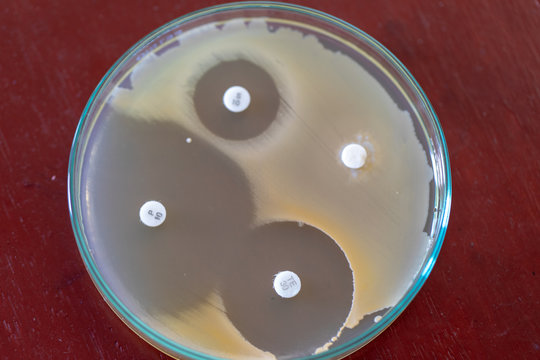
「ブドウ球菌」の画像 6,676 件の Stock 写真、ベクターおよびビデオ Adobe Stock

ブドウ球菌科( Staphylococcaceae)は、黄色ブドウ球菌などいくつかの医学的に重要な病原体を包含する ブドウ球菌(Staphylococcus)属を含むグラム陽性菌の科である。 Jeotgalicoccus、Macrococcus、Nosocomiicoccus、Salinicoccus及びブドウ球菌科の 5つの属は単球性であることが示されており、Gemellaは多毛性であるようである。
出典





ブドウ球菌科( Staphylococcaceae)は、黄色ブドウ球菌などいくつかの医学的に重要な病原体を包含する ブドウ球菌(Staphylococcus)属を含むグラム陽性菌の科である。 Jeotgalicoccus、Macrococcus、Nosocomiicoccus、Salinicoccus及びブドウ球菌科の 5つの属は単球性であることが示されており、Gemellaは多毛性であるようである。